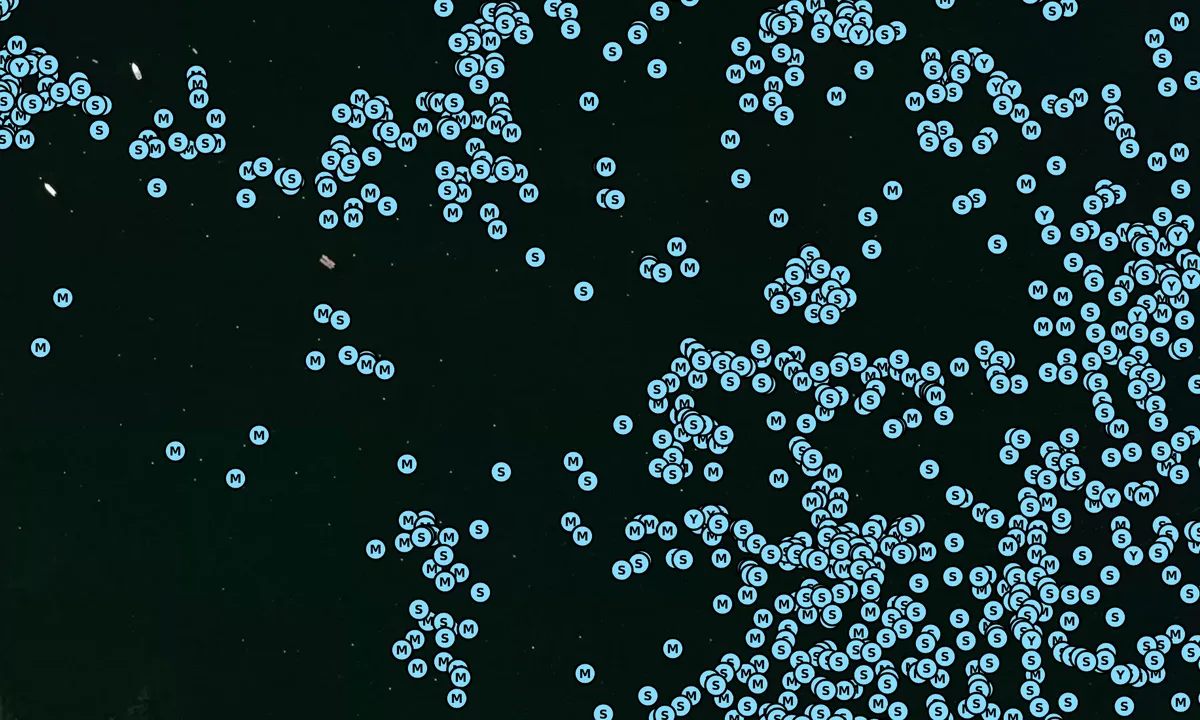
Satelite image of Rockland Harbor - 1

Rockland Harbor - 1
Naturhamn

Region: United States (9180), Maine (448), Knox (99) och Rockland (23)
Har du kunskap om denna hamn?
svenskhamnguide.se är skapad av seglargemenskapen, men det finns ingen information på denna sida ännu.
Om du svarar på några snabba frågor eller laddar upp ett foto kommer hamnen att uppdateras. Det tar bara en minut, med mestadels ja/nej-frågor och sidan är designad för små mobilskärmar.
Din kunskap är mycket värdefull för andra användare som söker information om Rockland Harbor - 1.

Beskrivningar och recensioner
Känner du till den här hamnen? Det är till stor hjälp för andra seglare om du lägger till en kort beskrivning eller recension av hamnen.
Karta över Rockland Harbor - 1

Vindskydd
Skydd nästa natt
69 poäng



Vill du veta hur vindpoängen fungerar? Då ska du läsa denna förklaring.
Vindprognoserna kommer från yr.no (Norges meteorologiska institut), och uppdaterades senast för 16 minuter sedan (Onsdag 27 Maj 20:14). Nästa nattresultat visar dig den sämsta timmen mellan 22:00 och 08:00 nästa natt. Vi rekommenderar att du kontrollerar flera källor för vindprognoser.windy.com är en bra hemsida för att visa större vindsystem.

De säkra vindriktningarna för denna hamn har bestämts av en algoritm, baserat på hur högt marken runt hamnen är. Det är för det mesta korrekt, men ibland är underliggande data om höjdnivåer inte tillräckligt bra för att fatta korrekta beslut. Det är till stor hjälp för andra om du kan validera eller justera de säkra vindriktningarna. You can see the data used by the algorithm to decide the safe wind directions by clicking here.
Senaste besök till Rockland Harbor - 1
Fre 29 Sep 2023 |
|
|
Lör 09 Sep 2023 |
|
|
Sön 03 Sep 2023 |
|
|
|
|
Sön 27 Aug 2023 |
|
|
The visits are retrieved from AIS data. You can click to see all visiting ships to Rockland Harbor - 1, as well as statistics about the ships that visits
Lägg till den här hamnen till en resa
Välj ett annat datum än idag
Viktigt: När du checkar in i en hamn lägger du till den på en resa på den här webbplatsen. Du bokar inte plats i gästhamnen.
Medverkande
Användare som bidragit till den här sidan:
svenskhamnguide.se uppdateras av båtlivet. När du lägger till information, en recension eller bilder på den här sidan listas du här med de andra bidragsgivarna (vi listar ditt användarnamn, som kan vara ditt riktiga namn eller en pseudonym).
Närmaste hamnar till Rockland Harbor - 1
Filtrera efter
Sortera efter
0 hamnar
Visa fler hamnar

CYGNUS [MMSI: 338415171]
CYGNUS [MMSI: 338415171]